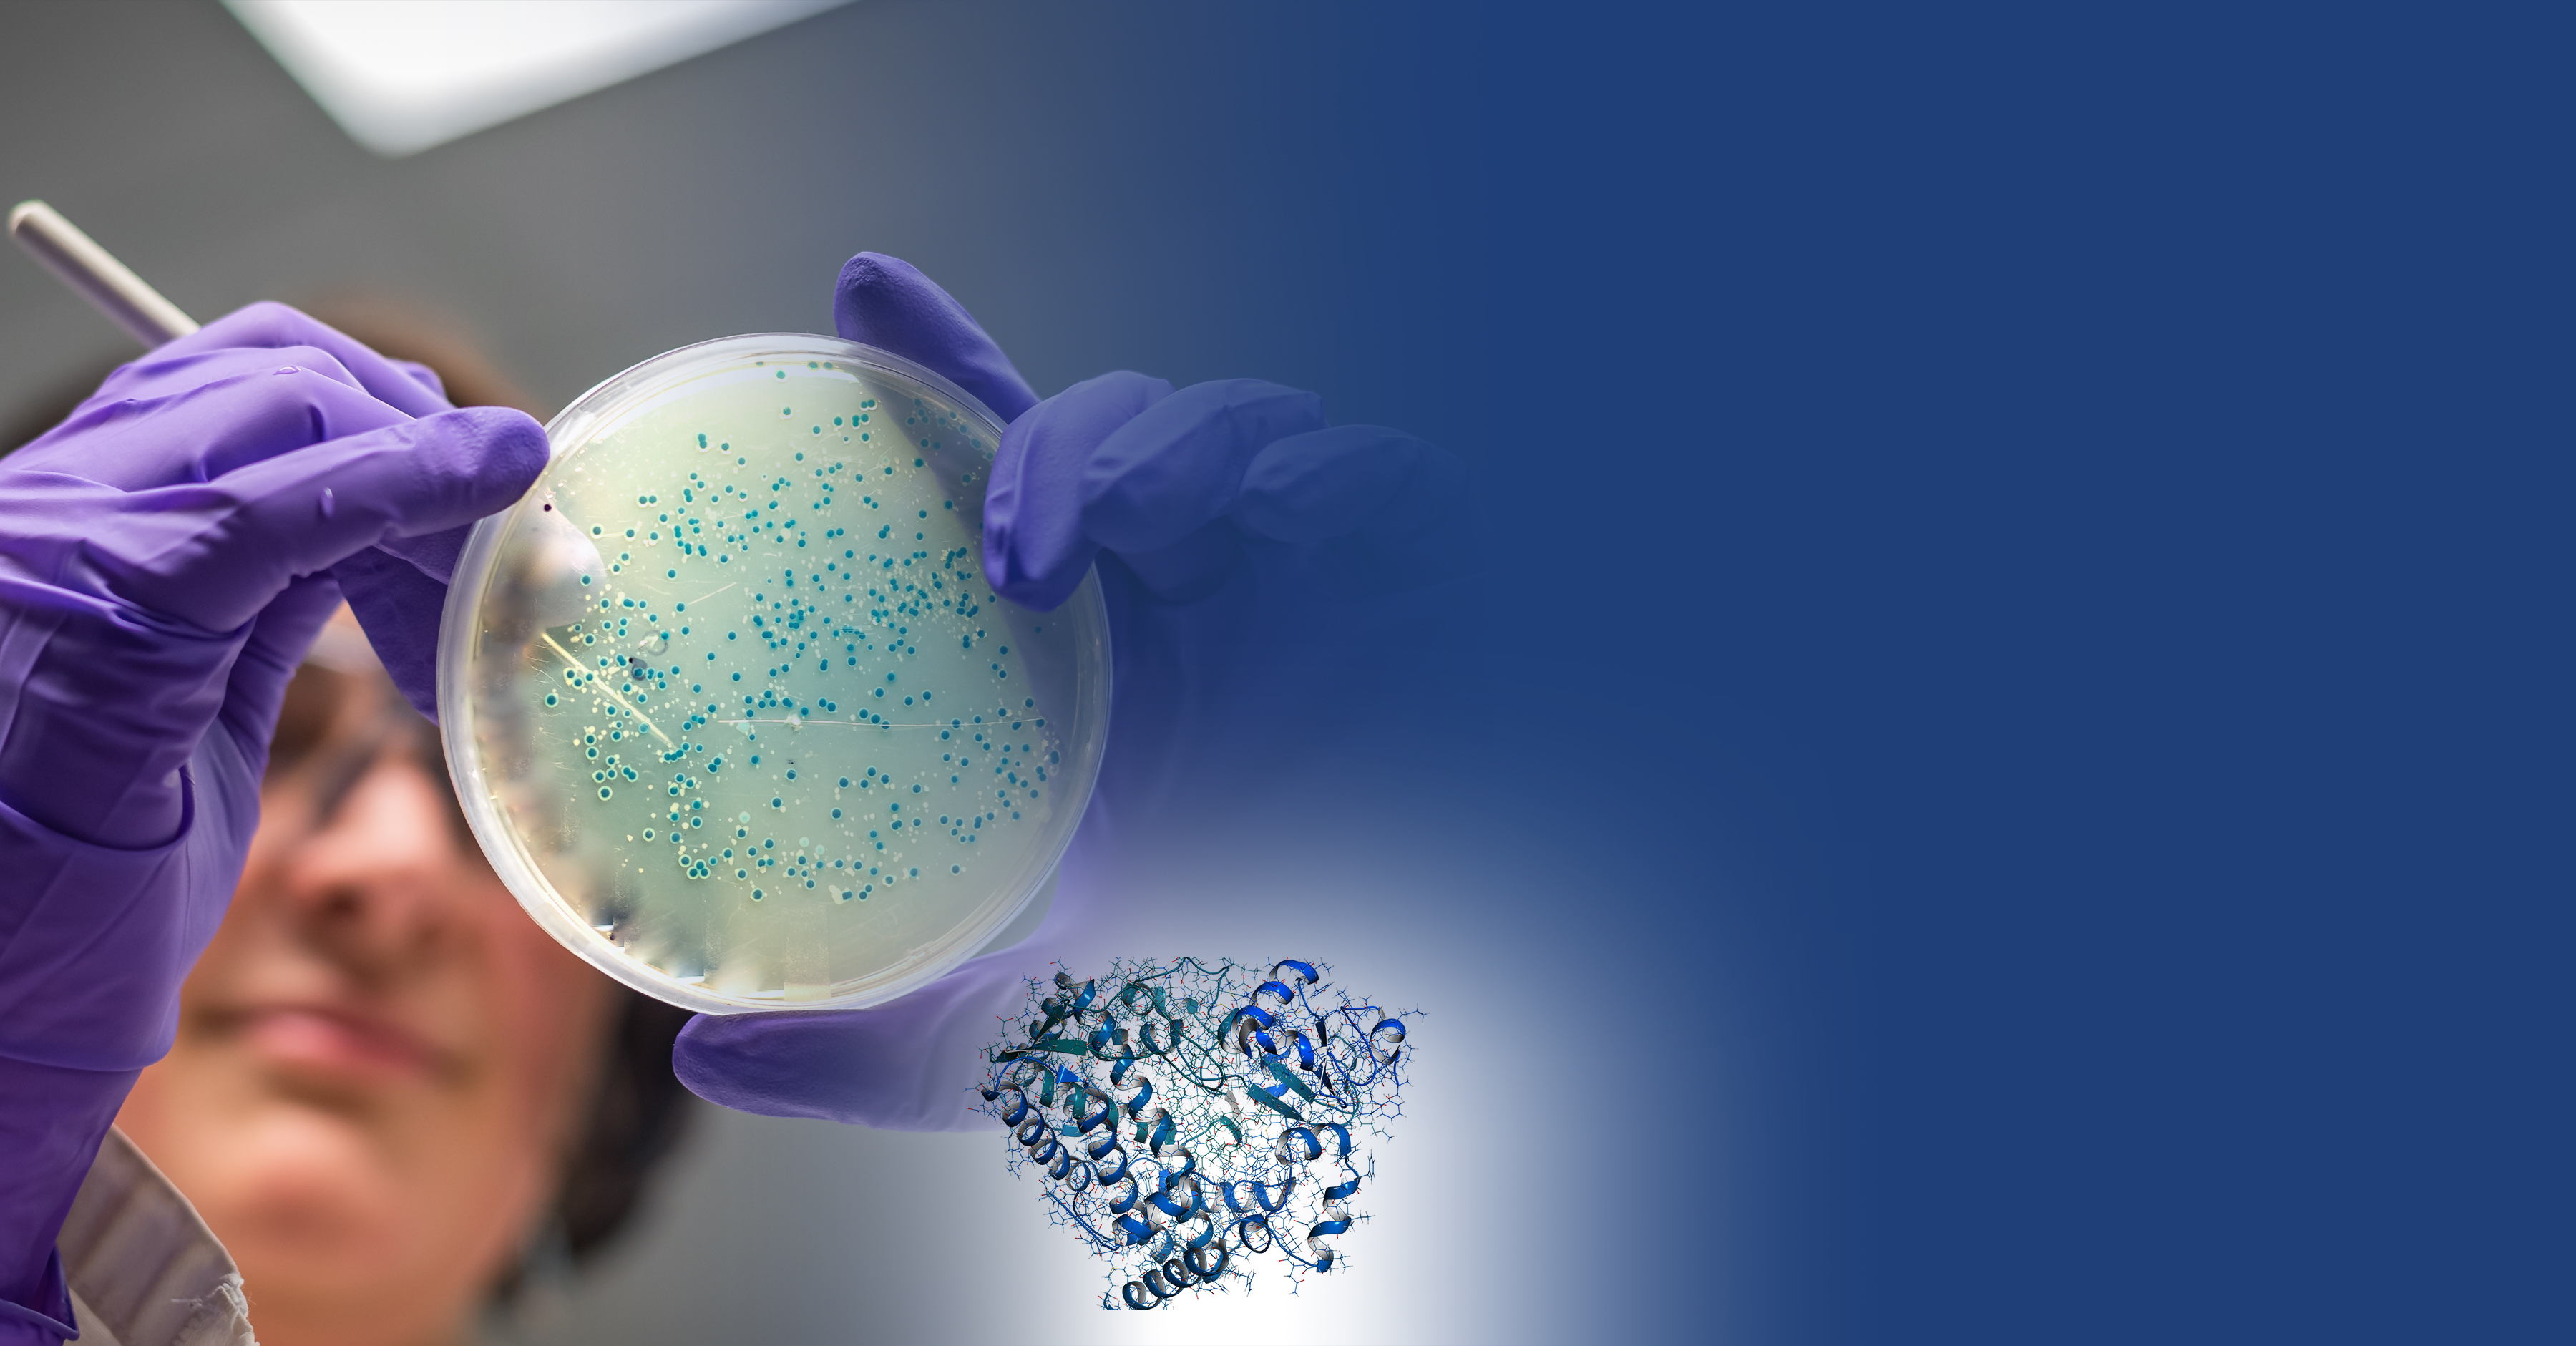

The program’s objective was to identify development candidate of degrader from hit expansion to candidate optimization against the Partner’s target as back-up for their clinical inhibitor asset. The key deliverable in the program was to demonstrate significant tumour growth inhibition (TGI) in a mouse efficacy study from the selection of multiple bioavailable degraders.
Hit expansion encountered with problems of target proteins family selectivity, poor chemical, plasma, microsomal and hepatocyte stability, high in-vivo clearance, and poor oral bioavailability. Key goals were, therefore, to achieve target specific family proteins selectivity, and improved in-vivo PK properties.
AIDD team first studied the SAR in hit expansion to come up with the length of linker for target specific family proteins selectivity. By understanding the contributing factors for stability, clearance and oral bioavailability of degraders, team explored with multiple SAR combinations of linkers, CRBN ligands and using multiple POI ligands (Figure 1) of the target inhibitors led to the identification of multiple degraders with higher oral bioavailability.
Furthermore, computational approach (Figure-2), developed binary complexes of protein of interest with E3-ligase, using PP docking and MD docking model. The optimized binary complex is utilized for docking of enumerated PROTACs. Selection and prioritization of PROTACs is dependent on protein-protein interactions, alignment and binding energy. Preferred and non-preferred PROTACs obtained from the analysis were prioritized for the synthesis.
By medicinal chemistry approach, variety of linkers and CRBN ligands position of attachment are proposed through the understand of structure activity relationship and alignment of PROTACs in binary complex for cellular activity. Explored variety of linear (PEG, alkyl etc) semi-rigid and rigid linkers for the understanding of Stability (chemical, plasma and microsome), solubility and permeability. PHI2 (flexibility descriptor) utilized as one of the key parameter for the PROTACs linkers selection. PROTACs showing good cellular activity, cell proliferation effect and pharmacokinetic properties were selected for the refining computational chemistry approach.
SAR learnings with target proteins and DMPK assays provided deeper insights into the three fragments of degraders (CRBN ligand, linker, and POI ligand – Figure 3) in terms of stability from rigid linker, basic nitrogen containing linker influence on PK properties and cell permeability from CRBN ligands. Physicochemical property like molecular weight, polar surface area optimization of degraders provided highly potent, selective, stable, low clearance and high oral bioavailability candidates.
The team was able to progress four compounds through the mouse efficacy studies demonstrating TGI driven by target protein degradation. Additionally, one of these molecules progressed towards a predevelopment candidate nomination.